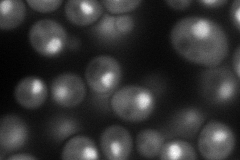
YPL139C
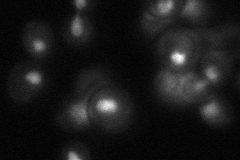
YPL139C
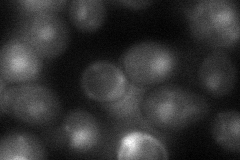
YPL139C
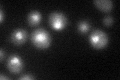
YPL139C

View description
Negative regulator of meiosis, required for repression of a subset of meiotic genes during vegetative growth, binding of histone deacetylase Rpd3p required for activity, contains a NEE box and a WD repeat motif; homologous with Wtm1p, Wtm2p
Localization:
Intensity:
Fold change:
Significance:
-
C’ GFP library in SD

nucleus26.43 -
N' NOP1pr-GFP in SD
cytosol,nucleus97.6651 -
N' TEF2pr-mCherry in SD

cytosol,nucleus268.266 -
N' NATIVEpr-GFP in SD
nucleus34.6877 -
N' TEF2pr-VC and Cyto-VN in SD
nucleus44.4351 -
C’ GFP library in SD+DTT
nucleus25.520.96No -
C’ GFP library in SD+H2O2

nucleus30.221.14No -
C’ GFP library in Starvation Media

nucleus33.51.26No -
C’ GFP library on the background of Pup2-DaMP

nucleus -
C’ GFP library on the background of CCT mutant

nucleus29.96621.13367No
